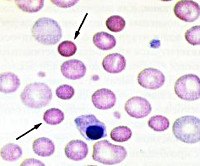

Другие названия и синонимы
Hereditary microspherocytosis, Болезнь Минковского-Шоффара.
МКБ-10 коды
|
|
Описание
Наследственный микросфеоцитоз. Это гемолитическая анемия, вызванная генетическим дефектом мембран эритроцитов и характеризующаяся непрерывным гемолизом. Клинические признаки включают бледность, пожелтение кожи, слизистых оболочек, боли в левой части живота из-за увеличенной селезенки и скелетной деформации. В молодом возрасте развивается желчнокаменная болезнь. Диагностика проводится с помощью общего анализа крови, определяющего осмотический иммунитет эритроцитов. Иногда требуется электрофорез мембранных белков. Основное лечение - удаление селезенки (спленэктомия).
Дополнительные факты
Наследственный микросфероцитоз (НМС, болезнь Минковского-Шоффара) является врожденным гематологическим заболеванием из группы мембранопатий. Болезнь впервые была подробно описана немецким терапевтом Оскаром Минковским в 1900 году, через 7 лет французский терапевт Анатоль Шоффар обнаружил снижение осмотической резистентности эритроцитов у пациентов с NMS. Распространенность этой патологии в среднем составляет 1: 2500 человек, чаще встречается в Японии, Африке, Северной Европе. Клинические проявления могут возникать в любом возрасте, но чаще встречаются в подростковом или взрослом возрасте. Мужчины страдают больше.
Причины
Основой наследственного микросфеоцитоза является мутация гена, кодирующего синтез одного из белков цитоскелета мембраны эритроцитов. Мутации разных генов происходят в разных семьях. Ген альфа цепи спектина находится в хромосоме 1 (локус Iq21), ген бета-цепи находится в хромосоме 14 (локус q22-q23), а ген анкирина находится в хромосоме 8 (локус 8p 11.2). Заболевание характеризуется аутосомно-доминантным типом наследования.
Предрасполагающие факторы включают в себя наличие наследственного микросфеоцитоза или бессимптомного носителя мутантных генов среди близких родственников пациента. Инфекционные патологии, прививки, тяжелый стресс могут вызвать обострение (гемолитический кризис) или первый симптом НМС у людей с легкой формой. У женщин обострения часто возникают во время беременности.
Предрасполагающие факторы включают в себя наличие наследственного микросфеоцитоза или бессимптомного носителя мутантных генов среди близких родственников пациента. Инфекционные патологии, прививки, тяжелый стресс могут вызвать обострение (гемолитический кризис) или первый симптом НМС у людей с легкой формой. У женщин обострения часто возникают во время беременности.
Патогенез
В результате ингибирования выработки мембранного белка проницаемость эритроцитов клеточной стенки для ионов натрия увеличивается, что приводит к набуханию и накоплению в них воды. Эритроциты меняют свою форму от двояковогнутой до сферической, они уменьшаются. Продолжительность их жизни сокращена до 8-10 дней (обычно с 90 до 120). Из-за потери эластичности и неспособности к деформации микросфеоциты в значительной степени подвержены внутриклеточному гемолизу. Они не могут проходить через суженные участки синусоиды селезенки и разрушаются макрофагами.
Из-за постоянного разрушения эритроцитов процессы кроветворения костного мозга компенсаторно усиливаются. Из-за хронического гемолиза высвобождается большое количество неконъюгированного билирубина, который отправляется в печень для секреции в желчь. Поэтому желчный пузырь начинает заполняться пигментированными камнями. При патологическом исследовании выявляется гиперплазия эритроидного зачатка костного мозга из трубчатых, плоских костей. Пульпа кровоснабжения выражена. Также часто отмечается гемосидероз внутренних органов.
Из-за постоянного разрушения эритроцитов процессы кроветворения костного мозга компенсаторно усиливаются. Из-за хронического гемолиза высвобождается большое количество неконъюгированного билирубина, который отправляется в печень для секреции в желчь. Поэтому желчный пузырь начинает заполняться пигментированными камнями. При патологическом исследовании выявляется гиперплазия эритроидного зачатка костного мозга из трубчатых, плоских костей. Пульпа кровоснабжения выражена. Также часто отмечается гемосидероз внутренних органов.
Классификация
Яркость клинической картины зависит от дефицита белка, наблюдаемого у пациента, и он является гетерозиготным или гомозиготным носителем мутантных генов. Согласно этим критериям различают следующие уровни тяжести наследственного микросфероцитоза:
Небольшой гемолиз, развивающийся у взрослых под влиянием провоцирующих факторов. Селезенка слегка увеличена. Уровень гемоглобина составляет от 100 до 120 г / л.
Умеренный гемолиз и спленомегалия. Кожа желтушная по цвету. Уровень гемоглобина составляет от 80 до 100 г / л.
Редкая форма. Тяжелый гемолиз, большие размеры селезенки, скелет деформирован. Критическое течение с большим количеством осложнений и вероятностью летального исхода характерно. Уровень гемоглобина составляет от 60 до 80 г / л. Существует необходимость в постоянных переливаниях крови.
• Бессимптомный (скрытый). Для этого вида человек даже не подозревает, что он болен. Эта форма характерна для гетерозиготных особей. Единственным симптомом может быть наличие небольшого количества микросфеоцитов, высокий ретикулоцитоз. Фактический уровень заболеваемости неизвестен.
Небольшой гемолиз, развивающийся у взрослых под влиянием провоцирующих факторов. Селезенка слегка увеличена. Уровень гемоглобина составляет от 100 до 120 г / л.
Умеренный гемолиз и спленомегалия. Кожа желтушная по цвету. Уровень гемоглобина составляет от 80 до 100 г / л.
Редкая форма. Тяжелый гемолиз, большие размеры селезенки, скелет деформирован. Критическое течение с большим количеством осложнений и вероятностью летального исхода характерно. Уровень гемоглобина составляет от 60 до 80 г / л. Существует необходимость в постоянных переливаниях крови.
• Бессимптомный (скрытый). Для этого вида человек даже не подозревает, что он болен. Эта форма характерна для гетерозиготных особей. Единственным симптомом может быть наличие небольшого количества микросфеоцитов, высокий ретикулоцитоз. Фактический уровень заболеваемости неизвестен.
Клиническая картина
Начало заболевания, как правило, прогрессирует. При латентной и легкой форме увеличение спинального кроветворения компенсирует постоянное разрушение эритроцитов, что помогает поддерживать уровень гемоглобина на соответствующем уровне. Степень выраженности клинической картины определяется степенью гемолиза. На переднем плане обычно появляется пожелтение кожи, склеры и слизистой оболочки рта с лимонно-шафранным оттенком. В течение длительного времени желтуха может быть единственным признаком наследственного микросфероцитоза.
Анемический синдром проявляется бледностью кожи, слизистых оболочек, симптомами гипотонии (слабость, головокружение, тахикардия). Селезенка почти всегда увеличивается, из-за чего пациент испытывает тянущие или болезненные боли в левом подреберье. Желтуха, спленомегалия, анемия составляют гемолитическую триаду. Часто печень увеличивается, но не так сильно, как селезенка, поэтому тяжесть и боль в правом подреберье незначительны.
Если заболевание проявляется в раннем детстве, развивается деформация костного скелета (стигма дисэмбриогенеза) - череп башни, укорочение мизинцев, широкий нос У взрослых пациентов с тяжелой НМС, которые не подвергались спленэктомии, В нижних трофических язвах иногда наблюдаются конечности (голень, лодыжка) из-за ухудшения микроциркуляции.
Яркие клиники, в частности, страдают гемолитическим кризисом, на который влияют различные провокационные факторы. Из-за массивного гемолиза температура тела пациента повышается, интенсивность желтухи увеличивается. Появляются симптомы отравления билирубином (потеря аппетита, рвота, мышечные боли, суставы). Из-за резкого увеличения селезенки боль усиливается и лопается. Уровень гемоглобина падает до критических значений, пациент может потерять сознание.
Ассоциированные симптомы: Боль в левом подреберье. Гипербилирубинемия. Ломота в мышцах. Низкая температура тела. Отсутствие аппетита. Протеинурия. Тяжесть в подреберье. Эритропения.
Анемический синдром проявляется бледностью кожи, слизистых оболочек, симптомами гипотонии (слабость, головокружение, тахикардия). Селезенка почти всегда увеличивается, из-за чего пациент испытывает тянущие или болезненные боли в левом подреберье. Желтуха, спленомегалия, анемия составляют гемолитическую триаду. Часто печень увеличивается, но не так сильно, как селезенка, поэтому тяжесть и боль в правом подреберье незначительны.
Если заболевание проявляется в раннем детстве, развивается деформация костного скелета (стигма дисэмбриогенеза) - череп башни, укорочение мизинцев, широкий нос У взрослых пациентов с тяжелой НМС, которые не подвергались спленэктомии, В нижних трофических язвах иногда наблюдаются конечности (голень, лодыжка) из-за ухудшения микроциркуляции.
Яркие клиники, в частности, страдают гемолитическим кризисом, на который влияют различные провокационные факторы. Из-за массивного гемолиза температура тела пациента повышается, интенсивность желтухи увеличивается. Появляются симптомы отравления билирубином (потеря аппетита, рвота, мышечные боли, суставы). Из-за резкого увеличения селезенки боль усиливается и лопается. Уровень гемоглобина падает до критических значений, пациент может потерять сознание.
Ассоциированные симптомы: Боль в левом подреберье. Гипербилирубинемия. Ломота в мышцах. Низкая температура тела. Отсутствие аппетита. Протеинурия. Тяжесть в подреберье. Эритропения.
Возможные осложнения
Наиболее распространенными осложнениями (50%) являются заболевания желчевыводящих путей и калькулезный холецистит, возникающие в результате выделения большого количества билирубина, выделяемого желчью разрушенными эритроцитами. Длительные переливания крови могут привести к перегрузке железом, вторичному гемохроматозу (цирроз печени, кардиомиопатия, сахарный диабет 2 типа). Трофические язвы на ногах в редких случаях способствуют развитию воспалительных бактериальных процессов в подкожном и внутримышечном волокне (флегмона, некротический фасциит).
Наиболее опасным состоянием, которое возникает при наследственном микросфероцитозе, является апластическая атака, вызванная инфекцией парвовирусом в19. Образование крови в костном мозге прекращается, содержание крови всех образующихся элементов (эритроцитов, лейкоцитов, тромбоцитов) резко уменьшается. Появляется кровотечение, глубокая анемия, высокая чувствительность к инфекционным агентам.
Наиболее опасным состоянием, которое возникает при наследственном микросфероцитозе, является апластическая атака, вызванная инфекцией парвовирусом в19. Образование крови в костном мозге прекращается, содержание крови всех образующихся элементов (эритроцитов, лейкоцитов, тромбоцитов) резко уменьшается. Появляется кровотечение, глубокая анемия, высокая чувствительность к инфекционным агентам.
|
|
Диагностика
Пациенты с болезнью Минковского-Шоффара подлежат обследованию у гематолога. При обследовании больного учитывают степень выраженности гемолитической триады, наличие деформации лицевого скелета. Проверяется, есть ли у этого близкого родственника это заболевание. Для подтверждения диагноза назначается дополнительный осмотр, который включает в себя:
При общем анализе крови обнаруживается снижение уровня эритроцитов, гемоглобина, увеличение ретикулоцитов (до 20%). Размер красных кровяных клеток уменьшается (менее 7 микрон). Морфологическая оценка мазка крови выявляет микросфероциты. Биохимический анализ крови показывает признаки гемолиза - высокая концентрация непрямой билирубина, лактатдегидрогеназы.
• Проверочный тест. Снижение осмотической стабильности эритроцитов выявлено в виде повышенной чувствительности к лизису в гипотонических растворах NaCl (0,4-0,6%). Также слабой является способность красных кровяных клеток фиксировать флуоресцентный краситель эозин-5-малеимид в тесте EMA. Электрофорез белков мембран эритроцитов позволяет точно определить дефицит определенного белка (спектрин, анкирин).
• Инструментальные исследования. УЗИ органов брюшной полости у пациента с любой формой наследственного микросоцитоза выявляет увеличение селезенки, а иногда и печени. Часто находит камни в желчном пузыре. На рентгенограмме костей черепа, трубчатых костей, признаки пролиферации костного мозга - расширение канала костного мозга, участки остеопороза, истончение коркового слоя.
Спектр патологий, исключаемых при болезни Минковского-Шоффара, довольно широк. Чаще всего необходимо дифференцировать НМС от аутоиммунной гемолитической анемии. Для этого проводится тест на антиглобулин (реакция Кумбса), чтобы исключить иммунную природу гемолиза. С NMS результат отрицательный. Легкие формы, сопровождающиеся только желтухой и легкой спленомегалией, следует отличать от доброкачественной гипербилирубинемии (синдром Гилберта). Перегрузка железом отличается от первичного (наследственного) гемохроматоза.
При общем анализе крови обнаруживается снижение уровня эритроцитов, гемоглобина, увеличение ретикулоцитов (до 20%). Размер красных кровяных клеток уменьшается (менее 7 микрон). Морфологическая оценка мазка крови выявляет микросфероциты. Биохимический анализ крови показывает признаки гемолиза - высокая концентрация непрямой билирубина, лактатдегидрогеназы.
• Проверочный тест. Снижение осмотической стабильности эритроцитов выявлено в виде повышенной чувствительности к лизису в гипотонических растворах NaCl (0,4-0,6%). Также слабой является способность красных кровяных клеток фиксировать флуоресцентный краситель эозин-5-малеимид в тесте EMA. Электрофорез белков мембран эритроцитов позволяет точно определить дефицит определенного белка (спектрин, анкирин).
• Инструментальные исследования. УЗИ органов брюшной полости у пациента с любой формой наследственного микросоцитоза выявляет увеличение селезенки, а иногда и печени. Часто находит камни в желчном пузыре. На рентгенограмме костей черепа, трубчатых костей, признаки пролиферации костного мозга - расширение канала костного мозга, участки остеопороза, истончение коркового слоя.
Спектр патологий, исключаемых при болезни Минковского-Шоффара, довольно широк. Чаще всего необходимо дифференцировать НМС от аутоиммунной гемолитической анемии. Для этого проводится тест на антиглобулин (реакция Кумбса), чтобы исключить иммунную природу гемолиза. С NMS результат отрицательный. Легкие формы, сопровождающиеся только желтухой и легкой спленомегалией, следует отличать от доброкачественной гипербилирубинемии (синдром Гилберта). Перегрузка железом отличается от первичного (наследственного) гемохроматоза.
Лечение
При уровнях гемоглобина ниже 70 г / л переливаются эритроциты, суспензия или отмытые эритроциты. При содержании гемоглобина менее 50 г / л они прибегают к переливанию цельной крови. Переливание крови следует проводить медленно, чтобы избежать гемолитических реакций. При длительных переливаниях крови хелатная терапия - дефероксамин, аскорбиновая кислота необходима для удаления избытка железа.
Для поддержания ремиссии (предотвращения кризиса) пациентам с тяжелой и средней тяжестью НМС назначают фиксированную дозу фолиевой кислоты. В случае апластического криза требуется дополнительное введение тромботического концентрата, стимуляторов лейкопоэза (филграстим) и антибиотиков широкого спектра действия (цефтриаксон). Трофические язвы лечат антисептическими растворами (фурацилином), мазями, содержащими антибиотики.
Основным радикальным видом лечения, обеспечивающим выздоровление больного, является тотальная спленэктомия (полное удаление селезенки). Он показан пациентам с частыми гемолитическими кризами, глубокой анемией, тяжелой гипербилирубинемией и спленомегалией. Оптимальный возраст для операции - 6 лет. Лапароскопическое вмешательство является предпочтительным, поскольку оно менее травматично. Частичная резекция и эмболизация селезеночной артерии не рекомендуется, поскольку она связана с высокой частотой рецидивов. Холецистэктомия показана при желчнокаменной болезни.
Для поддержания ремиссии (предотвращения кризиса) пациентам с тяжелой и средней тяжестью НМС назначают фиксированную дозу фолиевой кислоты. В случае апластического криза требуется дополнительное введение тромботического концентрата, стимуляторов лейкопоэза (филграстим) и антибиотиков широкого спектра действия (цефтриаксон). Трофические язвы лечат антисептическими растворами (фурацилином), мазями, содержащими антибиотики.
Основным радикальным видом лечения, обеспечивающим выздоровление больного, является тотальная спленэктомия (полное удаление селезенки). Он показан пациентам с частыми гемолитическими кризами, глубокой анемией, тяжелой гипербилирубинемией и спленомегалией. Оптимальный возраст для операции - 6 лет. Лапароскопическое вмешательство является предпочтительным, поскольку оно менее травматично. Частичная резекция и эмболизация селезеночной артерии не рекомендуется, поскольку она связана с высокой частотой рецидивов. Холецистэктомия показана при желчнокаменной болезни.
Лечение наследственного микросфероцитоза.
Пациенты с легкой и бессимптомной формой не нуждаются в лечении. Вам просто нужно регулярно посещать врача и делать клинический анализ крови. Пациенты с NMS от умеренной до тяжелой степени должны лечиться в гематологическом отделении. Развитие гемолитических апластических кризов из-за высокого риска смерти свидетельствует о переводе в отделение интенсивной терапии и отделение интенсивной терапии.Список литературы
1. Руководство по гематологии/ под ред. Воробьев А.И. 2005.
2. Анемии (клиника, диагностика, лечение)/ Стуклов Н. И., Альпидовский В. Огурцов П. П. 2013.
3. Анемия (от А до Я). Руководство для врачей/ Новик А.А., Богданов А.Н. 2004.
4. Патофизиология крови/ Шиффман Ф.Дж. 2000.
2. Анемии (клиника, диагностика, лечение)/ Стуклов Н. И., Альпидовский В. Огурцов П. П. 2013.
3. Анемия (от А до Я). Руководство для врачей/ Новик А.А., Богданов А.Н. 2004.
4. Патофизиология крови/ Шиффман Ф.Дж. 2000.